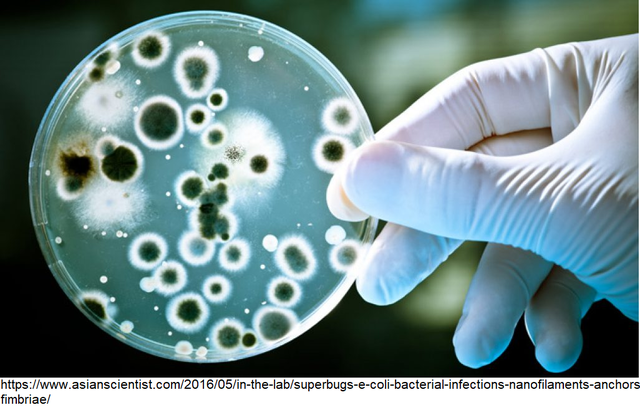
Uso del control microbiológico en sistemas de enfriamiento.

-
Durante la revolución industrial; Comenzó con el tratamiento interno del agua de la caldera utilizada para generar vapor. , los ingenieros hicieron una práctica de tirar algunas patatas en la caldera después de cada limpieza
-
Las primeras patentes para el tratamiento interno del agua para calderas. La mayoría de ellos implicaron el uso de taninos orgánicos naturales para el control de la escala de temperaturas en la caldera.
-
Se emitió una patente para el uso de fosfato disódico
-
Se emitió una patente de fosfato trisódico.
-
Se reconoció generalmente que la fragilización era causado por una combinación de estrés metálico y alta concentración de sodio hidróxido.
-
Las torres de enfriamiento comenzaron a utilizarse en el tratamiento de aguas, el ajuste del pH fue uno de los primeros tratamientos utilizados, sirviendose de ácidos y alcalis.
-
Se llevo a cabo el primer estudio científico de la neutralización de aminas para controlar el dióxido de carbono la corrosión en las líneas de condensado.
Se sugirieron derivados de fenol para el uso del control microbiológico en sistemas de enfriamiento y se introdujo el programa coordinado de control de fosfato / pH. -
En la decada de 1950 Ryznar introdujo su índice de estabilidad para el agua de refrigeración.
-
Se implementaron ligninas procesadas para mejorar el control de la escala de temperaturas en la caldera asi como la aplicación de polímeros acrílicos sintéticos de bajo peso molecular para reemplazar los taninos y las ligninas naturales en el acondicionamiento de los lodos de agua en la caldera.
-
Se investigó el efecto de la actividad microbiológica sobre la corrosión, incluyendo el efecto de las bacterias reductoras de sulfato.
-
Investigaciones de polifosfatos como inhibidores de corrosión en sistemas de refrigeración bajo variadas condiciones de temperatura, pH y transferencia de calor.
-
Se lograron avances importantes en el control de depósitos en sistemas de agua de refrigeración, la introducción de fosfonatos, acrilatos y varios orgánicos, sintéticos y naturales se generalizarón.
-
Dos temas que comenzaron a dominar el mercado de tratamiento de agua industrial fueron la energía y el medio ambiente.
seopto por la limpieza de la caldera con el fin de mejorar la tranferencia de calor y disminuir el uso de combustibles y se reemplazaron los inhibidores de corrosion de zinc y cromato con tratamientos de menor eficacia pero mas amigables con el medio ambiente. -
El uso de cromato fue inicialmente prohibido en aplicaciones HVAC y luego en todas las aplicaciones de la torre de enfriamiento industrial por razones para el cuidado del medio ambiente y la salud
-
El uso de la química basada en bromo para reemplazar el uso de la química con base en el cloro, se hizo popular debido a la eficacia mejorada del bromo a un pH más alto.
-
Se inició una tendencia definida hacia un pH alto y altamente alcalino esto requirió agentes de control de escala más efectivos para trabajar bajo estas condiciones de estrés.
-
La consolidación las compañías de tratamiento de aguas nacionales Había seis compañías principales conocidas como el "Six Pack". Estos incluyen Nalco, Betz, Calgon, Dearborn, Drew y Mogul. Ellos dominaron el mercado de tratamiento de agua en EE. UU.
-
Es un grupo de empresas independientes del tratamiento de agua, que hoy ofrecen capacitación de nivel técnica, oportunidades de networking, eventos educativos, asistencia de mercadotecnia, monitoreo legislativo, cumplimiento regulatorio legal, e imagen.
-
El tratamiento de agua en EE. UU. se convirtió en una gran corporación de suministro de equipos a través de cientos de adquisiciones.
-
ChemTreat de Virginia crece rápidamente y se convierte en una importante empresa en el tratamiento de agua en los Estados Unidos.
-
El énfasis en la reutilización del agua se intensificó asi como el uso de tecnologías que incluyen microfiltración, ultrafiltración y ósmosis inversa se hicieron mucho más populares y asequibles.
-
Mogul fue comprado por Diversey y luego por Nalco a su vez Betz fue comprado Dearborn en 1996.
-
Suez Lyonnaise des Eaux Group compró Nalco and Calgon Corporation. Suez es una empresa francesa que más tarde cambió su nombre por Ondeo con la división de tratamiento de agua llamada Ondeo-Nalco.
-
GE compró Hércules (BetzDearborn) y se convirtió en GE Water Technologies. GE Water también compró Glegg y Osmonics; ambos son empresarios del tratamiento de agua industrial. Ondeo vendió Nalco a un grupo de inversionistas y el nombre Nalco fue restaurado.
-
Veolia Environnement amplió sus capacidades de tratamiento de agua en América del Norte con la compra de Crown Solutions, una empresa integrada de tratamiento industrial del agua que proporciona servicios de alta calidad desde 1984.
Plan projects on a visual timeline
Map milestones, phases, deadlines, and key events in one place so the sequence is easier to see and share. Timetoast is a timeline maker for work, school, research, and stories.